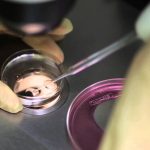

- info@drcengizsagiroglu.com
- Suadiye Mah. Plaj Yolu Sk. Plaj Yolu Apt. 14/3Kadıköy/İstanbul
Kadıköy’de Tüp Bebek Doktoru Seçerken Sorulması Gereken 7 Soru
Son Yazılarımız
2026 Güncel İstanbul Tüp Bebek Fiyatları
İstanbulda IVF Tedavisi
Şubat 22, 2026
Kadıköy Tüp Bebek Doktoru
Şubat 22, 2026
Bizimle İletişime Geçin
- +90 555 052 6458
- info@drcengizsagiroglu.com
- Suadiye Mah. Plaj Yolu Sk. Plaj Yolu Apt. 14/3Kadıköy/İstanbul
İletişim
+90 555 052 6458
info@drcengizsagiroglu.com
Adres
Suadiye Mah. Plaj Yolu Sk. Plaj Yolu Apt. 14/3Kadıköy/İstanbul
Kadıköy’de Tüp Bebek Doktoru Seçerken Sorulması Gereken 7 Soru
Kadıköy’de tüp bebek doktoru arayışında olan çiftler için karar süreci yalnızca konum seçimi değildir. Tüp bebek tedavisi, kişisel değerlendirme ve düzenli takip gerektiren bir süreçtir. Bu nedenle hekim seçimi bilinçli yapılmalıdır.
Bu yazıda, kadıköy tüp bebek doktoru seçerken sorulması gereken temel soruları ele alıyoruz.
Tedavi Planı Kişiye Özel mi Oluşturuluyor?
Tüp bebek tedavisi standart bir uygulama değildir. Yaş, hormonal değerler ve sperm parametreleri tedavi planını belirler. Kişisel planlama, sürecin önemli bir parçasıdır.
Süreç Boyunca Aynı Hekim mi Takip Edecek?
Bazı merkezlerde ekip bazlı model uygulanırken, bazı uzmanlar süreci birebir yürütmektedir. Düzenli hekim takibi çiftler için önemli olabilir.
IVF Sürecinin Aşamaları Açık Şekilde Anlatılıyor mu?
IVF tedavisi; yumurta geliştirme, toplama, laboratuvar aşaması ve embriyo transferi gibi basamaklardan oluşur. Sürecin şeffaf şekilde anlatılması önemlidir.
İstanbul genelinde uygulanan ivf tedavisi istanbul süreci hakkında detaylı bilgiye ilgili sayfadan ulaşılabilir.
Düşük AMH Durumunda Yaklaşım Nasıl?
Düşük over rezervi olan hastalarda planlama farklı yapılmalıdır. Doz ayarlamaları ve zamanlama önemlidir.
Erkek Faktörüne Bağlı Durumlarda Hangi Yöntem Tercih Ediliyor?
Mikroenjeksiyon (ICSI) gibi yöntemler, sperm parametrelerine göre belirlenir.
Tekrarlayan Başarısız Denemelerde Değerlendirme Yapılıyor mu?
Önceki denemelerin analizi, yeni planlama açısından önemlidir.
Lokasyon ve Düzenli Kontrol Kolaylığı Var mı?
Kadıköy, Anadolu Yakası’nda ulaşım açısından avantaj sağlayabilir. Düzenli kontroller sürecin önemli bir parçasıdır.
Bireysel değerlendirme ve düzenli hekim takibi önemlidir.
Hayır, kişisel özelliklere göre planlanır.